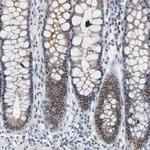
FOXP1 Antibody in Immunohistochemistry (Paraffin) (IHC (P))

Search
Invitrogen
FOXP1 Polyclonal Antibody
{{$productOrderCtrl.translations['antibody.pdp.commerceCard.promotion.promotions']}}
{{$productOrderCtrl.translations['antibody.pdp.commerceCard.promotion.viewpromo']}}
{{$productOrderCtrl.translations['antibody.pdp.commerceCard.promotion.promocode']}}: {{promo.promoCode}} {{promo.promoTitle}} {{promo.promoDescription}}. {{$productOrderCtrl.translations['antibody.pdp.commerceCard.promotion.learnmore']}}
图: 1 / 14
FOXP1 Antibody (PA5-52006) in ICC/IF

Please note: We are reviewing Western blot images included in the antibody testing data in our catalog, including those provided by third parties. Unless expressly labeled or annotated as “raw-unedited”, Western blot images included in the antibody testing data in our catalog may have been edited, optimized or otherwise adjusted for presentation.
产品信息
PA5-52006
种属反应
宿主/亚型
分类
类型
抗原
偶联物
形式
浓度
规格
纯化类型
保存液
内含物
保存条件
运输条件
RRID
产品详细信息
Immunogen sequence: QMQQLQQQHL LSLQRQGLLT IQPGQPALPL QPLAQGMIPT ELQQLWKEVT SAHTAEETTG NNHSSLDLTT TCVSSSAPSK TSLIMNPHAS TNGQLSVHTP KRESLSHEEH PHSHPLYGHG VCKWPGCEAV CEDFQSFLKH LNS
Highest antigen sequence identity to the following orthologs: Mouse - 95%, Rat - 97%.
靶标信息
This gene belongs to subfamily P of the forkhead box (FOX) transcription factor family. Forkhead box transcription factors play important roles in the regulation of tissue- and cell type-specific gene transcription during both development and adulthood. Forkhead box P1 protein contains both DNA-binding- and protein-protein binding-domains. This gene may act as a tumor suppressor as it is lost in several tumor types and maps to a chromosomal region (3p14.1) reported to contain a tumor suppressor gene(s). Alternative splicing results in multiple transcript variants encoding different isoforms.
仅用于科研。不用于诊断过程。未经明确授权不得转售。
生物信息学
蛋白别名: FLJ23741; Fork head related protein like B; Forkhead box protein P1; Forkhead box protein P1 (FOXP1); Forkhead-related transcription factor 1; Glutamine rich factor 1; Mac-1-regulated forkhead; MFH; MGC12942; MGC88572; MGC99551
基因别名: 3110052D19Rik; 4932443N09Rik; AI461938; AW494214; FOXP1; HSPC215
UniProt ID: (Rat) Q498D1, (Mouse) P58462
Entrez Gene ID: (Rat) 297480, (Mouse) 108655




